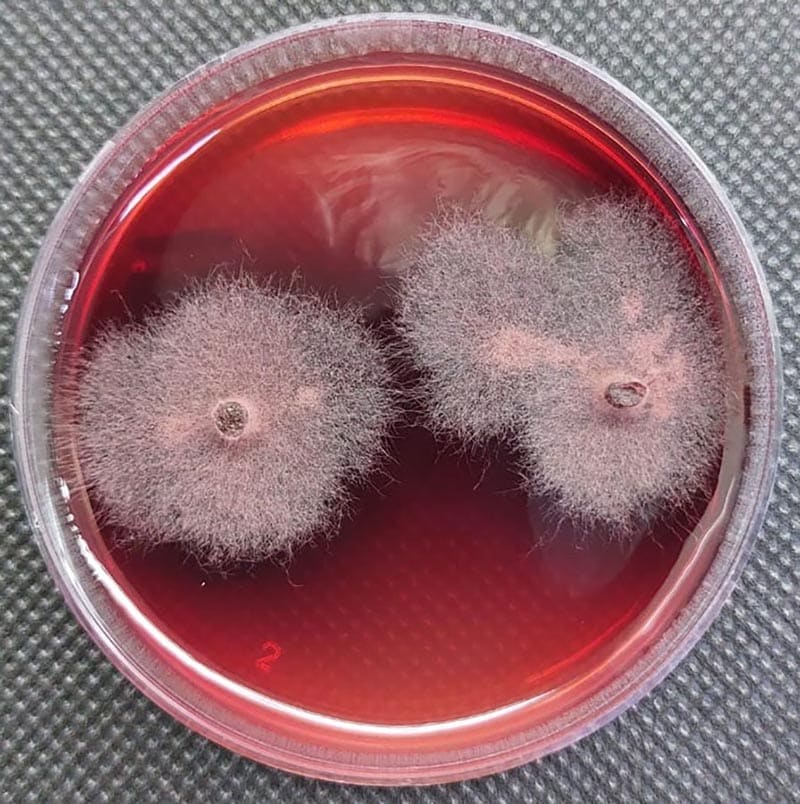

Mais lidas 🔥

Frio intenso no Hemisfério Norte pode indicar um inverno mais rigoroso no Brasil em 2026?

Demanda pelo "ejiao"
Cientistas contestam decisão judicial que libera abate de jumentos; peles vão para a China

Meio Ambiente
Último dia da andada do caranguejo-uçá chama atenção no ES

Previsão do tempo
Quinta ZCAS de 2026 provoca chuva intensa em oito estados até março

Anuário do Agronegócio Capixaba 2025
Turismo rural no Espírito Santo: as histórias de quem está construindo a história

Um fungo microscópico que vive escondido dentro de plantas pode ajudar a criar novos defensivos agrícolas mais seguros e sustentáveis. A descoberta foi feita por pesquisadores da Universidade Federal de Minas Gerais (UFMG), da Embrapa Meio Ambiente e do Departamento de Agricultura dos Estados Unidos (USDA) após analisarem um fungo retirado de uma planta medicinal do gênero Piper, comum em regiões tropicais.
Dentro desse fungo, os cientistas encontraram três substâncias capazes de impedir o crescimento de plantas daninhas e de combater fungos que atacam lavouras. Uma delas é totalmente inédita na ciência e nunca havia sido descrita antes. Os pesquisadores a apelidaram de “composto 2”. Nos testes, essa substância teve um desempenho parecido — e, em alguns casos, até superior — ao de herbicidas sintéticos já vendidos no mercado.
Aliados invisíveis das plantas
Os fungos estudados são chamados de endofíticos. Eles vivem dentro das plantas sem causar doença e, muitas vezes, ajudam a protegê-las contra pragas. Em troca, ganham abrigo e alimento. Esse tipo de relação já desperta o interesse da ciência há anos, mas vem ganhando força com a busca por alternativas mais sustentáveis na agricultura.
“Esses microrganismos escondem um potencial enorme para gerar novos produtos naturais úteis ao campo”, explica Luiz Henrique Rosa, professor da UFMG.
O fungo descoberto em Minas Gerais
O fungo analisado pelos pesquisadores pertence ao gênero Fusarium, muito comum no solo e em plantas. Ele foi encontrado em 2017, dentro de uma planta coletada no Parque Estadual da Floresta do Rio Doce, em Minas Gerais, e depois identificado em laboratório usando técnicas de DNA.
Mesmo sem conseguir descobrir exatamente sua espécie — algo comum porque o grupo é bastante complexo — os cientistas seguiram com os testes para entender quais substâncias ele produz.

Três substâncias promissoras
Depois de isolar os compostos presentes no fungo, os pesquisadores testaram seus efeitos em sementes de alface e grama, dois vegetais usados em experimentos de herbicidas. Os três compostos impediram a germinação das sementes, o que mostra uma alta capacidade herbicida.
A substância inédita, o “composto 2”, foi a que apresentou os melhores resultados. Em testes com lentilha-d’água, usada pela indústria para medir toxicidade e eficiência de produtos agrícolas, ela se mostrou mais potente que herbicidas muito conhecidos, como o glifosato.
O composto também funcionou contra fungos que atacam plantas, como o Colletotrichum fragariae, responsável por doenças em diversas culturas. Em alguns casos, sua ação foi mais forte que a de fungicidas naturais usados como referência.
A importância para o agro
O uso de pesticidas sintéticos começou nos anos 1940 e ajudou a aumentar a produção de alimentos. Mas também trouxe problemas: contaminação ambiental, riscos à saúde e resistência de pragas.
Hoje, o mundo precisa produzir mais comida, mas com menos impacto ambiental. Por isso, cresce a busca por bioinsumos — produtos agrícolas feitos a partir de organismos vivos ou suas substâncias.
“Os compostos que encontramos mostram um potencial real para se tornarem novas ferramentas para uma agricultura mais sustentável”, explica Sonia Queiroz, pesquisadora da Embrapa Meio Ambiente.
Próximos passos
Embora os resultados sejam promissores, o caminho até um possível produto comercial ainda é longo. Os cientistas destacam que são necessários mais testes, avaliações de segurança e estudos de campo. Também será preciso entender melhor como cada substância age e se ela pode ser modificada para funcionar ainda melhor.
Mesmo assim, o estudo abre uma nova porta. “Microrganismos que ninguém vê podem se transformar em grandes aliados da agricultura”, avaliam os autores.
Fronteira científica
Os resultados iniciais abrem caminho para pesquisas mais aplicadas, incluindo a avaliação do desempenho dos compostos em condições de campo e sua integração em formulações comerciais. Também há interesse em explorar o fenômeno de hormese observado nos testes, em que doses baixas estimularam o crescimento vegetal, indicando potencial para usos diferenciados.“Estamos diante de uma fronteira científica em que microrganismos invisíveis podem se transformar em aliados estratégicos da agricultura”, concluem os autores.





